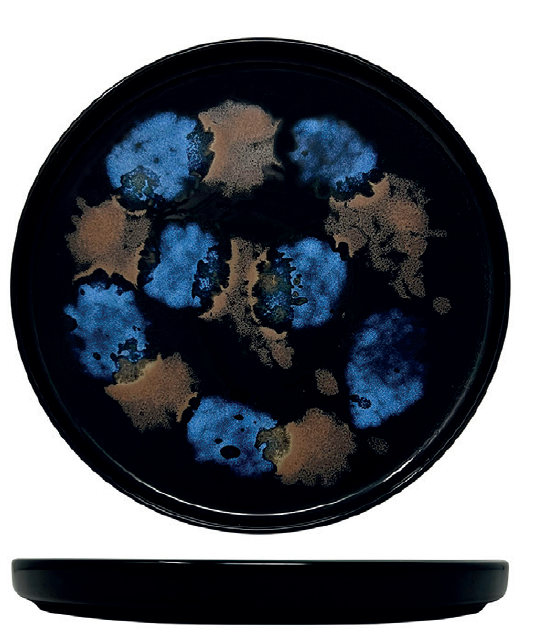

ICaLIA Tableware Ltd.
Eat Good. Eat Stylish.
Encanto - Darwin Plate cm.27 - 06027512
Encanto - Darwin Plate cm.27 - 06027512
SKU:06027512
🇮🇹 This product is available only as a pre-order. Delivery timelines vary depending on availability, import schedules. Estimated timing will be confirmed by email after purchase.
Couldn't load pickup availability
Artistic, bold, and truly captivating, the Encanto collection transforms the table into a canvas of color and emotion. Inspired by abstract art and natural textures, this line blends deep tones with luminous accents to create a striking and contemporary visual impact.
Set on a rich black background, the design features organic bursts of intense blue and warm bronze-like shades, reminiscent of mineral surfaces, flowing pigments, or cosmic landscapes. Each piece feels unique, with patterns that appear almost hand-painted, giving the collection a dynamic and expressive character.
Encanto is made for statement dining. Perfect for modern restaurants and creative chefs, it enhances presentation by creating contrast and drama, allowing dishes to stand out while being framed by a truly artistic surface.
Crafted from high-quality porcelain and finished with durable decoration, the collection ensures long-lasting brilliance and resistance to intensive use, making it ideal for both hospitality environments and sophisticated everyday settings.
Share